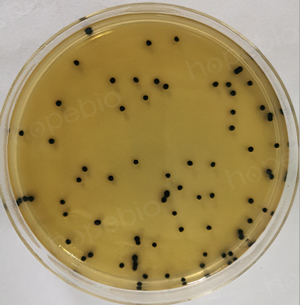
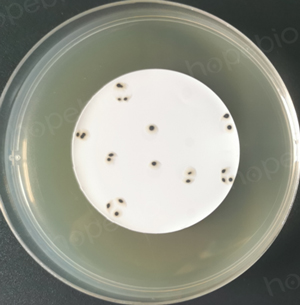

海博微信公众号
海博微信公众号
 海博天猫旗舰店
海博天猫旗舰店


 海博微信公众号
海博微信公众号
 海博天猫旗舰店
海博天猫旗舰店




一、产气荚膜梭菌简介
产气荚膜梭菌为厌氧芽孢菌,是引起食源性胃肠炎最常见的病原之一。可引起食物中毒爆发,常与公共饮食有关。例如:学校的自助食堂和养老院的护理病房,最常发生于儿童和老人,患者常剧烈腹绞痛和腹泻,少数脱水死亡。
该菌的形态为:两端钝圆、直杆状、革兰氏阳性,卵圆形芽孢位于菌体中央或近端,不比菌体明显膨大,在人和动物活体组织内或在含血清的培养基内生长时有可能形成荚膜,对其染色后显微镜下的形态如图1。

图1 产气荚膜梭菌的显微形态
产气荚膜梭菌广泛分布于环境中,引起人类感染的大多是畜禽肉类和鱼类,牛奶也可因污染而引起中毒,其原因是食品加热不彻底,使芽孢大量繁殖所致。
该菌属于厌氧性细菌,但对厌氧程度的要求并不太严,甚至在低氧的环境内也能生长。在普通培养基上能生长,若添加葡萄糖、血液,则生长更好。
在食品检验和饮用天然矿泉水检验中,都有相应的标准要求对样品中产气荚膜梭菌的数量进行检验。怎样从样品中将产气荚膜梭菌有效地分离出来,是进行检验和鉴定的先决条件。本文主要介绍与产气荚膜梭菌分离有关的2种培养基,对配方和使用方法方面进行对比描述。
二、培养基对比介绍
能够对产气荚膜梭菌进行分离的培养基主要有2种,分别为胰䏡-亚硫酸盐-环丝氨酸琼脂(TSC)和亚硫酸盐-多粘菌素-磺胺嘧啶琼脂(SPS),这两种培养基的异同及产气荚膜梭菌在这两种培养基上的菌落形态如表1、图2。
表1 两种产气荚膜梭菌培养基的异同
|
比较项目 |
培养基名称 |
|
|
TSC |
SPS |
|
|
配方成分 |
胰胨、大豆胨、酵母粉、 焦亚硫酸钠、柠檬酸铵、琼脂 |
胰酪蛋白胨、酵母浸粉、 柠檬酸铁铵、亚硫酸钠、琼脂 |
|
添加剂 |
D-环丝氨酸溶液 |
多粘菌素B和磺胺嘧啶钠 |
|
pH值 |
7.6±0.2 |
7.0±0.1 |
|
相关标准 |
GB 4789.13-2012 食品微生物学检验 产气荚膜梭菌检验 |
GB 8538-2016 饮用天然矿泉水检验方法 产气荚膜梭菌检验 |
|
使用方法 |
平皿倾注法 |
滤膜法 |
|
菌落特征 |
黑色菌落 |
|
|
|
|
TSC琼脂 |
SPS琼脂 |
图2 产气荚膜梭菌在两种培养基上的菌落形态
三、注意事项
(1)使用不同的标准检验不同的样品,需要选用的培养基不同,要根据实际目的选用合适的分离培养基;
(2)虽然这两款培养基基本配方很相近,但它们的pH和所配套使用的添加剂是不一样的,使用时要注意区别,不要混用;
(3)两种培养基的使用方法不一样,使用时要选用与培养基要求一致的分离方法;
(4)因为这两款培养基都是用于分离产气荚膜梭菌,为了有效地将目标菌分离出来,一定不要忘记采用厌氧培养的方式进行培养。可以配套使用海博公司生产的厌氧产气包和厌氧培养袋。
相关产品:
胰䏡-亚硫酸盐-环丝氨酸琼脂基础(TSC)-点击查看产品详情
亚硫酸盐-多粘菌素-磺胺嘧啶琼脂基础(SPS)-点击查看产品详情
注:本文属海博生物原创,未经允许不得转载。
上一篇:氧化酶试验的操作方法及注意要点
| 相关文章: | ||



